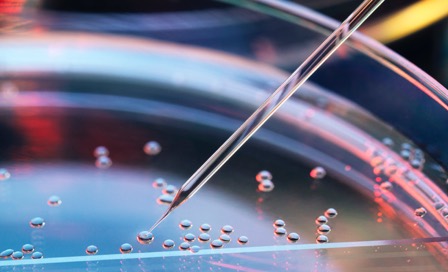
Close up on a petri dish with some bacteria showing.

How Are Clinical Trials Approved?
The Food and Drug Administration (FDA) and the Office of Human Research Protection (OHRP) develop the policies and guidelines for all medical research. An Institutional Review Board reviews and approves all study-related documents, such as protocols, informed consent forms, physicians’ credentials and eligibility and patient recruitment materials.
Phases of a clinical trial:
- PHASE 1: Is the treatment safe and effective? Emphasizing safety, only a small number of participants receive the new research treatment. Researchers determine how best to safely deliver the treatment.
- PHASE 2: How well does the treatment work? Researchers examine the effectiveness of the treatment as well as its side effects on the particular disease or condition being evaluated.
- PHASE 3: Is the treatment potentially better than the treatments currently available? Participants in a phase 3 trial are randomly assigned to different treatment groups to find out if the new treatment is better than the standard treatment.
- PHASE 4: What are the long-term side effects and risks of the treatment? If a new treatment is approved by the FDA, researchers continue to monitor it to learn how it works over the long term.
Patient safety in clinical trials
As you consider joining a trial, you must first know that the fundamental principle of any trial is the safety and well-being of the trial participant. This takes priority over the interests of the scientific research. Having a full understanding – not only of the risks, but also the safeguards and the potential benefits of participating in clinical research – allows patients to make a truly informed decision with the confidence.
All clinical trial participants are guaranteed the same level of care non-participants receive.
Patient rights and informed consent
The informed consent process protects participants. It is a process that researchers use to provide potential and enrolled participants with information about a clinical study. This information helps people decide if they want to enroll or continue to participate in the study. It should provide enough information for a person to understand the risks of, potential benefits of, additional procedures, tests, and assessments as well as alternatives to the study. In addition to the informed consent document, the process may involve recruitment materials, verbal instructions, question-and-answer sessions, and activities to measure participant understanding.
In general, a person must sign an informed consent document before joining a study to show he or she has received and understands information on the risks, potential benefits, and alternatives. Signing the document and providing consent is not a contract. Participants may withdraw from a study at any time, even if the study is not over.